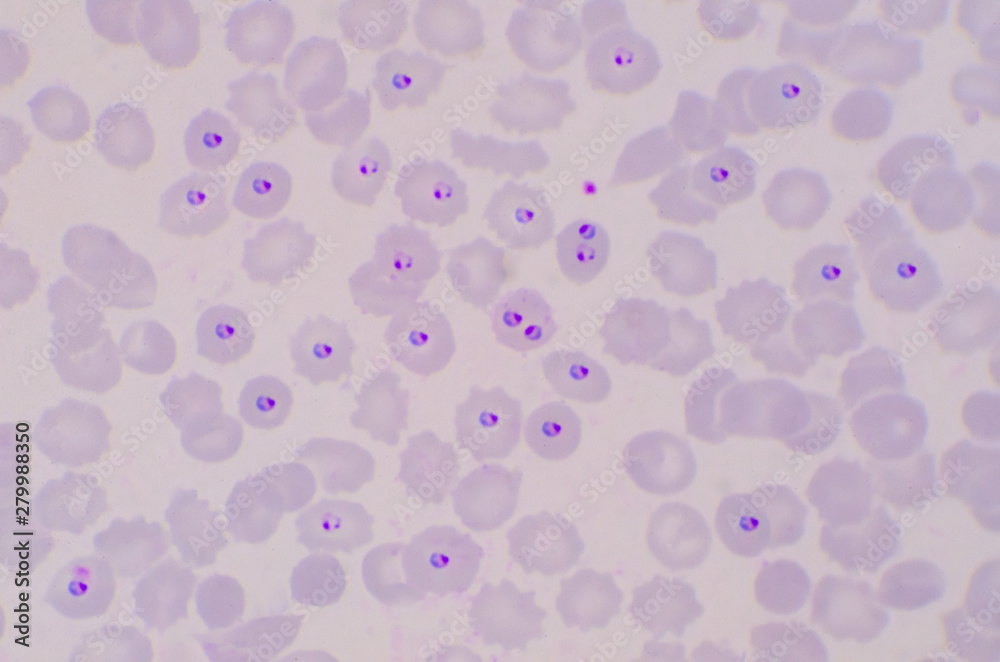

-
Marken & Merch
- Filmposter
- Batman
- Spider-Man
- Star Wars
- Harry Potter
- MARVEL
- DISNEY
- Pokémon
- Alles zeigen
- Musik
- Queen
- Rolling Stones
- AC/DC
- Beatles
- Bob Marley
- Iron Maiden
- Metallica
- Alles zeigen
- Anime & Manga
- Attack on Titan
- Pokémon
- Demon Slayer
- Jujutsu Kaisen
- Death Note
- Dragon Ball Z
- My Hero Academia
- Alles zeigen
- Comic
- Batman
- Spider-Man
- Superman
- Captain America
- Die Rächer
- MARVEL
- Wonder Woman
- Alles zeigen
- Gamingposter
- Assassin's Creed
- Nintendo
- Playstation
- Online Spiele
- Xbox
- Minecraft
- Sonic
- Alles zeigen
- Poster für Kinder
- Harry Potter
- Minecraft
- Lilo & Stitch
- DISNEY
- Die Eiskönigin
- Mickey Mouse
- Prinzessin
- Alles zeigen
-
Kunstdrucke
- Nach Thema
- Abstrakte Illustrationen
- Schwarz-weiß Kollektionen
- Reise-Poster
- Zitate und Texte
- Ruf der Natur
- Collagen
- Line Art
- Man Cave
- Mode
- Motive für Kinder
- Romantische Poster
- Sportliche Illustrationen
- Magazine Cover
- Women Power
- Tiere
- Tägliche Inspiration für dein Heim und Büro
- Mit Stil
- Bauhaus
- Öko-Stil
- Retro- und Vintage-Stil
- Asiatische Atmosphäre
- Skandinavischer minimalismus
- Art Deko Stil
- Boho-Stil
- Pariser Eleganz
- Tropisches Paradies
- Pop Art Stil
- Provence Stil
- Harmonie und Gelassenheit
- Romantischer Burg Stil
- Industrie Stil
-
Wandbilder
- Leinwandbilder
- Leinwandbilder
- Mehrteilige Leinwände
- Leinwandbilder -60 %%
- Alles zeigen
- Wandbilder
- Personalisierte Leinwand
- Gerahmte Poster -20 %%
- Kunstbilder
- Mehrteilige Leinwände
- Rahmen und Aufhänger
- Kunstbilder
- Florent Bodart
- Paul Cézanne
- Claude Monet
- Pierre-Auguste Renoir
- Sam Toft
- Leonardo da Vinci
- Alfons Mucha
- Hieronymus Bosch
- Gustav Klimt
- Wassily Kandinsky
- Leonetto Cappiello
- Vincent van Gogh
- Katsushika Hokusai
- Alles zeigen
-
Fotokunst
- Nach Thema
- Schwarz-Weiß-Eleganz
- Tiere
- Natur & Landschaft
- Reise um die Welt
- Liebesbeweis
- Alltagsmomente
- Macro
- Exotisches Abenteuer
- Minimalistische Schönheit
- Old school
- Panoramaposter
- Welt der Geschmäcker
- In den Bergen
- Blick von oben
-
Poster
- Rahmen und Aufhänger
- Rahmen auf Lager
- Posterhalter
- Accessoires
- Wanddekorationen
- Metallschilder
- Poster-Set
- Türposter und Türtapeten
- Möbel Sticker
- XXL-Poster
- Panoramaposter
- Gerahmte Poster -20 %%
- Marken & Merch
- Filmposter
- Musik
- Anime & Manga
- Comic
- Gamingposter
- Poster für Kinder
- Sport
- Prominente
- Poster
- Bestseller - TOP
- Neuheiten
- Ihre Fotos drucken
- Marken & Merch
- Letzte Chance für -60%%
- Ausverkauf bis zu -80%%
- Wanddekorationen
- Rahmen und Aufhänger
- Motive
- Abstrakte Kunst
- Architektur
- Auto - Moto - Aero - Poster, Wandbilder
- Erotische Poster
- Fantasy & Mystery
- Flaggen
- Für dein Gewerbe
- Geschichte und Religion
- Kunstbilder
- Kunstdrucke
- Landkarten
- Lustige Poster
- Mode
- Motivations- und Sprücheposter
- Nahrungsmittel und Getränke
- Natur und Landschaft
- Partys und Feiertage
- Prominente
- Reisen
- Romantische Poster
- Schwarz-weiß Poster
- Sport
- Tiere
- Universum
- Weltmetropolen und Städte
- Wissenschaft und Schule
-
Fototapeten
- Fototapeten -60 %%
- Bestseller
- Sticker
- Designerwahl
- Film Fototapeten
- Superhelden
- Animiert
- Serien
- Fantasy
- Fototapeten nach Thema
- Auto - Moto - Aero - Poster, Wandbilder
- Universum
- 3D Fototapeten
- Architektur
- Spielthemen
- Musik Fototapeten
- Weltkarten
- Motive für Kinder
- Natur und Landschaft
- Kunstfototapeten
- Muster & Verzierungen
- Tiere
-
-20 %Kalender 2026
- 3D Kalender
- Adventskalender
- Kalender - Auto, Motorrad
- Kalender - Erotik
- Kalender - Film & TV
- Kalender - Gaming
- Kalender - Künstler
- Kalender - Menschen
- Kalender - Musik
- Kalender - Reisen
- Kalender - Retro & Vintage
- Kalender - Spirituelles
- Kalender - Sport
- Kalender - Städte
- Kalendere - Tiere
- Alles zeigen
-
Tassen & Geschirr
- Geschirr
- Blechdosen und Brotdosen
- Flaschen
- Flaschenöffner
- Untersetzer
- Gläser
- Schnapsgläser
- Teller & Schalen
- Geschirr nach Motiv
- Anime geschirr
- Auto-Moto Geschirr
- Retro Geschirr
- Geschirr berühmter Künstler
- Fantasy geschirr
- Film und TV
- Fotografien
- Gaming-Gerichte
- Teller für Kinder
- Musik
- Comic
- Sport Geschirr
- Humor geschirr
- Neuheiten
-
Mode
- Mode
- Hoodies & Pullover
- Kappen & Hüte
- Winterklamotten
- Socken
- Hosen
- Schlafanzüge und Schlafzubehör
- Bademäntel und Handtücher
- Taschen & Rucksäcke
- Portemonnaies
- Schmuck & Beauty-Accessoires
- Regenschirme
- Gaming-Ärmel
- Unterwäsche
- Neuheiten
- T-shirts & Tops
- Damen T-Shirts
- Herren T-Shirts
- Kindershirts
- T-Shirts – Unsere Kollektion
- Foto-T-Shirt
- T-shirts -60 %%
- T-Shirts nach Marken
- Musik T-Shirts
- Anime T-Shirts
- Film- & TV-T-Shirts
- Gaming T-Shirts
- Harry Potter
- Star Wars
- Der Herr der Ringe
- MARVEL
- Batman
- T-Shirts nach Motiv
- T-Shirts mit berühmten Künstlern
- T-Shirts mit Sportmotiven
- Abstrakte T-Shirts
- T-Shirts mit asiatischen Motiven
- T-Shirts mit Line Art
- T-Shirts Essen & Trinken
- T-Shirts mit Tieren
- T-Shirts Auto Moto
- T-Shirts mit Kindermotiven
- T-Shirts mit Flaggen
- Lustige T-Shirts
- T-Shirts mit Zitaten
- Bauhaus T-Shirts
- Pop-Art T-Shirts
- Solidarität mit der Ukraine
-
T-shirts & Tops
- Hoodies & Pullover
-
Kappen & Hüte
-
Winterklamotten
- Socken
- Hosen
- Schlafanzüge und Schlafzubehör
- Bademäntel und Handtücher
-
Taschen & Rucksäcke
-
Portemonnaies
-
Schmuck & Beauty-Accessoires
- Regenschirme
- Gaming-Ärmel
-
Mode nach Motiven
-
Kleidung für:
- Unterwäsche
- Neuheiten
- Alles zeigen
-
 T-Shirts – Unsere Kollektion
T-Shirts – Unsere Kollektion
 Damen T-Shirts
Damen T-Shirts
 Herren T-Shirts
Herren T-Shirts
 Musik T-Shirts
Musik T-Shirts
 Film- & TV-T-Shirts
Film- & TV-T-Shirts
 Gaming T-Shirts
Gaming T-Shirts
-
Geschenke & Spiele
- Geschenke & Spiele
- Fotogeschenke
- Gutscheine
- Spielzeuge
- Perfekte Geschenke für
- Weihnachten
- Geschenke für Männer
- Geschenke für Frauen
- Geschenke für Kinder
- Geschenke für Pärchen
- Geschenke für Sammler
- Geschenke für Schüler
- Geschenke für Haustiere
- Merch
- Heimaccessoires
- Metallschilder
- Geschenksets
- Kleine und günstige Geschenke
- Figuren
- Repliken & Sammlerstücke
- Spielzeuge
- Tassen & Geschirr
- Kalender 2026 -20 %%
- Bürobedarf & Schreibwaren
- Blech Retro Geschenke
- Puzzles
- Taschen & Rucksäcke
- Notizbücher
- Künstlerbedarf
- Gerahmte Poster -20 %%
- Spielzeuge
- Puppen
- MGA's Miniverse
- LEGO
- Stofftiere
- Actionfiguren und Spielzeug
- Modellautos
- CarTuned
- Hot Wheels
- Spielkarten
- NERF
- Brettspiele
- Bilderwürfel
-
Für dein Gewerbe
- Für dein Gewerbe
- Schönheit & Wohlbefinden
- Hochzeitsstudio
- Gastgewerbe
- Ärzte
- Wissenschaft und Schule
- Fitness-Studio
- Helden der Straße
- Büro
- Experten & Geschäftsleute
- B2B Partners
- Schönheit & Wohlbefinden
- Kosmetische Studios
- Tattoo Studio
- Friseurgeschäft
- Wellness & Spa
- Friseur
- Nagelstudio
- Fitness-Studio
- Fitness und Fitness Studio
- Ästhetik im Sport
- Sportliche Illustrationen
- Automobilist
- Yoga
- Tanz
- Fußball
- Rahmen & Einrahmungen
- Fotogeschenke

Die Farben können immer etwas von den Farben auf deinem Bildschirm abweichen.
Sticker Plakat Plasmodium blood parasite ring form stage infected redblood cells von toeytoey
Weitere Druckoptionen auswählen
Produktbeschreibung
Sticker Plakat
Die Aufkleber sind originell und multifunktional. Sie können als Plakat oder Tapete an der Wand oder als Aufkleber auf Möbeln oder Türen verwendet werden. Einfache Anwendung – einfach aufkleben und abziehen, ohne Klebstoff zu verwenden. Sie hinterlassen keine Flecken an der Wand. Sie lassen sich einfach mit einer Schere in jede gewünschte Form schneiden und können mit einem feuchten Tuch gereinigt werden. Zum Drucken der Aufkleber verwenden wir hochwertige, 100% umweltfreundliche Farben, die auch für Kinderzimmer geeignet sind.Die Leinwand wird sorgfältig auf einen robusten Holzrahmen gespannt, der in zwei Tiefen erhältlich ist – 2 cm für ein dezenteres Aussehen oder 4 cm für einen markanteren Effekt. Hochwertige Materialien und präzise Handwerkskunst gewährleisten eine lange Lebensdauer. Ein Leinwandbild ist eine großartige Wahl und eine stilvolle Dekoration für jedes Interieur.
Kundenbewertungen

4.7 / 5
(3 816 Bewertungen)
Angezeigte Bewertungen für: Foto
Nehmen Sie am Instagram Fotowettbewerb teil und gewinnen Sie einen Gutschein über 40 €!


1. Foto auf Instagram hochladen.
2. Unser Profil markieren: @europostersde_merch
3. Gewinnen!
Den Gewinner losen wir jeden Monat aus. Wir drücken die Daumen!
Kontakt
FAQ
Über uns
Zahlung und Lieferung
AGB
Rückgabe und Rücksendung
Datenschutzerklärung
Aktionen und Rabatte
Treueprogramm
Bewertungen von Ihnen
Rahmen & Einrahmungen
Sticker
Impressum
Kollaborationen
Für Künstler und Fotographen
Für Influencer und Affiliates
Für Bands und andere Marken
Für B2B Partner
Europosters – Dekoriere dein Leben
Seit 1999 ist Europosters einer der Top Verkäufer von Postern, Wanddrucken and lizensiertem Merchandise aus der Tchechischen Republik und auch in ganz Europa. Wir bieten eine vielfältige Selektion von Film, Sport oder Videospiel Postern aller Größen an, sowie originale Artikel für wahre Fans von Harry Potter, Comics oder der ganzen Warner Bros. Familie. Wir wissen genau das unsere Tassen, Figuren, Puzzles und Kleidung die besten Geschenke für jederman sind, egal für welches Alter, Geschlecht oder Interessen. Und wenn du dich für Inneneinrichtungsdesign interessierst, bist du bei uns auch am richtigen Platz! Täglich drucken wir Wanddrucke, Gemälde, Illustrationen, Fotografien und Kunstreproduktionen und senden sie durch ganz Europa in über 25 Länder um unsere Kunden zufrieden zu stellen!
© 1999–2025 Europosters. Alle Rechte vorbehalten.
Wir belohnen loyale Kunden!
Mit der Registrerung stimmst du unserer Datenschutzrichtlinie zu..












































































